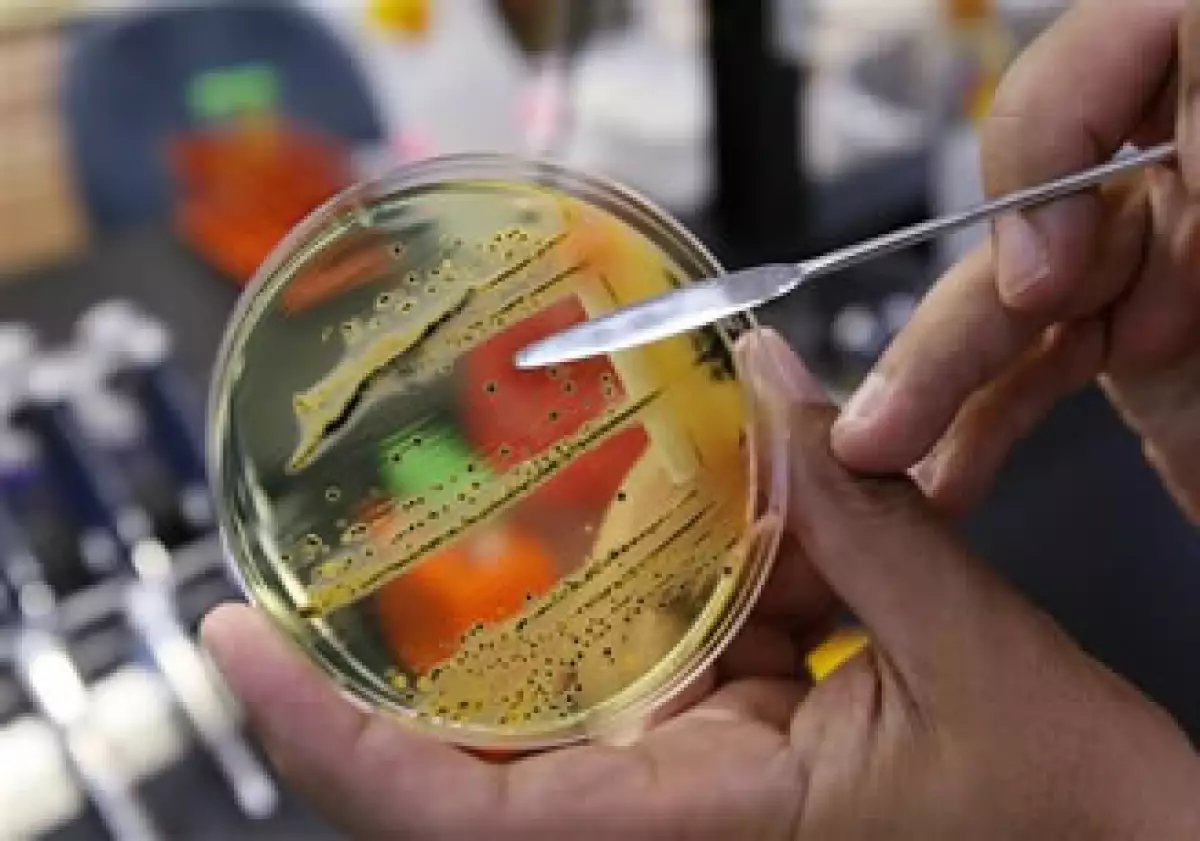

La E. coli podría ser la cepa más letal
Más de 1,600 personas han sido infectadas por una cepa tóxica de la bacteria E.coli que ha dejado al menos a 17 personas muertas y que podría ser la más letal hasta el momento en la historia de la humanidad, dijeron este viernes funcionarios de salud. Alemania está en el centro del brote. Pero la fuente exacta de la enfermedad aún es un misterio y los consumidores de todo el mundo parecen cada vez más nerviosos.
Unas 1,624 personas en Europa y Estados Unidos se han enfermado hasta el momento, probablemente debido a la ingestión de vegetales y ensaladas contaminados. La OMS dijo que la cepa era rara, que se había visto antes en humanos, pero nunca en un tipo de brote como este.
Se espera que la cifra de muertos aumente cuando Alemania actualice las cifras más tarde en el día, después de un feriado público del jueves. Expertos dicen que la fuente posiblemente esté en Alemania.
La gente también se ha enfermado en Austria, Dinamarca, Francia, Holanda, Noruega, España, Suecia, Suiza, el Reino Unido y Estados Unidos.
"Todos estos casos, excepto dos, son de personas que residen o han visitado recientemente el norte de Alemania durante el período de incubación para la infección -típicamente 3 a 4 días después de la exposición- o en un caso, tuvo contacto con un visitante del norte de Alemania", dijo la OMS en un comunicado.
La bacteria de la E.coli por sí sola es inofensiva, pero la cepa que está enfermando a la gente en Europa tiene la capacidad de pegarse a las paredes intestinales desde donde bombea toxinas, en algunos casos provoca una diarrea sangrienta severa y otras complicaciones.
Robert Tauxe del Centro para el Control y Prevención de Enfermedades de Estados Unidos, que ha estado trabajando con funcionarios de salud alemanes desde la semana pasada, dijo que la cepa posiblemente es la más letal que se conoce en términos de cantidad de muertes registradas.
"Creo que lo es", dijo a Reuters cuando se le preguntó sobre la posibilidad. El dijo que no estaba claro cómo la bacteria se volvió tan resistente.
Disputa comercial
El brote ha tensado las relaciones comerciales y Rusia fue criticada por la UE después de que prohibió las importaciones de vegetales crudos desde Europa y acusó a Bruselas de no poder manejar la crisis.
Funcionarios alemanes culparon inicialmente de la infección a pepinos contaminados importados desde España, pero posteriormente dieron pie atrás y pidieron disculpas a Madrid.
Las infecciones por E.coli pueden propagarse de persona a persona, pero sólo por lo que se conoce como la ruta fecal-oral. Expertos en salud en Alemania han recomendado a los consumidores que eviten comer vegetales crudos.
El brote está provocando infecciones severas y en varios de los casos, complicaciones que afectan la sangre y los riñones. El síndrome hemolítico urémico (SHU), que frecuentemente lleva a la falla renal y puede ser letal, ha sido diagnosticado en cientos de los casos.
Muchos pacientes han sido hospitalizados, varios de ellos han necesitado de cuidados intensivos, incluida la diálisis debido a las complicaciones renales.
La cepa es parte de una clase de bacterias conocidas como Escherichia coli enterohemorrágica o verotoxigénica (STEC), que produce un veneno conocido como la toxina Shiga.
"El problema de salud pública inmediato es la identificación de la fuente de infección para que pueda ser controlada", dijo Robert Hall, un experto en control de enfermedades en Victoria, Australia.
El dijo que esto se logra con una combinación de investigaciones epidemiológicas, microbiológicas y medioambientales. "Estas son todas tareas de alta preparación que deben realizarse rápidamente y que casi siempre se hacen con gran cantidad de publicidad", declaró.